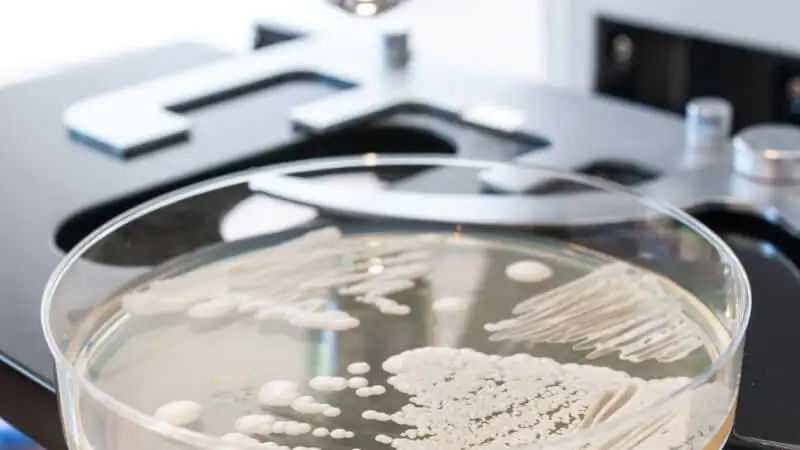

Kandydoza - przebieg, diagnostyka i dieta
6/27/2019
Candida albicans - modny postrach?
Candida albicans jest szeroko rozpowszechnionym drożdżakiem, który fizjologicznie występuje w mikroflorze jelit, żeńskich drogach rodnych, na skórze i błonach śluzowych. Do rodzaju Candida należą również m.in. C. glabrata, C. krusei, C. guilliermondii, C. parapsilosis, C. tropicalis, C. pseudotropicalis, C. lusitaniae, C. dubliniensis.
W przypadku osób zdrowych grzyby te nie stanowią jakiegokolwiek zagrożenia, dlatego niekoniecznie trzeba się martwić, jeżeli badania wykażą jedynie ich obecność, czym jednak niektórzy “specjaliści” starają się nas wystraszyć. Tak naprawdę dopiero nieograniczony rozrost Candida albicans jest niebezpieczny.
Komu zagraża kandydoza?
Do kandydozy (inaczej drożdżycy) dochodzi u osób ze znacznie osłabioną odpornością bądź nadmierną podatnością na zakażenia, do czego dochodzi w następujących przypadkach:
- zaburzenia odporności nabyte (np. AIDS) lub wrodzone (np. PGA),
- długotrwała antybiotykoterapia,
- leczenie immunosupresyjne (np. chemioterapia, sterydy),
- zaburzenia metaboliczne (np. cukrzyca),
- zaburzenia hormonalne (np. nadczynność przytarczyc, niedoczynność tarczycy, niedoczynność nadnerczy),
- niedożywienie i niedobory żelaza, kwasu foliowego, witaminy C,
- uszkodzenia błony śluzowej (w tym dożylne stosowanie narkotyków),
- wentylacja mechaniczna płuc,
- neutropenia (stan obniżenia granulocytów obojętnochłonnych we krwi),
- choroba nowotworowa (zwłaszcza układu krwiotwórczego),
- zabiegi chirurgiczne w obrębie jamy brzusznej i klatki piersiowej,
- długo utrzymywane cewniki wewnątrznaczyniowe i moczowe, żywienie pozajelitowe,
- rozległe oparzenia,
- marskość wątroby.
Ponadto, zakażeniem zagrożone są noworodki i dzieci o małej masie urodzeniowej.
Kandydoza jest niestety bardzo trudna do zdiagnozowania, przez co wiąże się ze znacznym stopniem śmiertelności. Dlatego najważniejsze jest jej zapobieganie w przypadku osób z obniżoną odpornością. Należy więc pamiętać, że Candida albicans może przenosić się pomiędzy osobami.
Różne typy grzybicy
Niepohamowany rozrost Candida albicans może występować w obrębie konkretnych narządów wewnętrznych bądź układów, a także istnieje możliwość kandydemii, czyli sytuacji, gdy drożdżaki są obecne we krwi - stan też może współistnieć z kandydozą narządową. Ponadto, istnieje również ryzyko kandydozy rozsianej, która dotyczy jednocześnie różnych narządów.
Kandydoza w obrębie układu sercowo-naczyniowego
Zagrożenie Candida w układzie sercowo-naczyniowym dotyczy głównie osób posiadających protezy zastawkowe. Zwykle do rozwinięcie infekcyjnego zapalenia wsierdzia spowodowanego kandydozą dochodzi już w 5-6 tygodni od operacji. Z tego powodu można uznać, że źródłem zakażenia mogła być właśnie operacja.
Kandydoza układu moczowego
Układ moczowy może zostać zakażony Candida szczególnie u osób z cukrzycą, w trakcie antybiotykoterapii bądź posiadających cewnik w pęcherzu moczowym. Wówczas możliwe jest rozpoznanie kandydurii, czyli obecności grzybów w posiewie z moczu. Nie zawsze ich obecność świadczy o groźnym zakażeniu, a usunięcie cewnika czy zakończenie antybiotykoterapii może spowodować ich ustąpienie. W rzadszych przypadkach kandyduria jest objawem zakażenia nerek - wówczas współistnieje z kandydemią.
Grzybicze zapalenie stawów
Grzyby stanowią rzadką przyczynę zapalenia stawów. Zwykle jeśli do tego dojdzie, zajmują jeden staw. Niestety w ramach leczenia może być konieczne usunięcie zainfekowanych tkanek oraz ewentualnej endoprotezy.
Zapalenie płuc wywołane przez Candida
Kandydoza może zająć płuca w przypadku obecności cewników lub drenów. Objawami będą kaszel, duszność i gorączka, a w RTG klatki piersiowej obraz zagęszczenia płata płuc bądź ogniska zacienień miąższowych.
Grzybicze zapalenie opon mózgowo-rdzeniowych
Do zapalenia opon mózgowo-rdzeniowych dochodzi przez zakażenie krwiopochodne bądź w przypadku urazów głowy. Przyczyną jest najczęściej rodzaj Candida, ale również Cryptococcus neoformans i Aspergillus. Zakaźność w przypadku zapalenia grzybiczego jest niewielka. Typowymi objawami są silne bóle głowy, gorączka, trudności z oddychaniem, nudności, wymioty, spowolniona akcja serca. Niestety rokowanie w przypadku grzybiczego zapalenia opon mózgowo-rdzeniowych jest złe.
Kandydoza dróg rodnych
Grzybica jest częstym problemem również ginekologicznym. Kandydozą zwykle objęte są srom i pochwa. Zakażenie wiąże się z upławami, świądem, bolesnym oddawaniem moczu. Wówczas do diagnostyki wykorzystuje się wymaz z dróg rodnych.
Grzybicze zapalenie jamy ustnej
Drożdżaki w jamie ustnej występują u nawet do 50% dorosłych i u ok. 65% dzieci. Również niemowlęta mogą być zakażone - głównym sposobem przekazania grzybów jest oblizywanie smoczka przez rodzica, sprawdzanie temperatury pokarmów czy całowanie dziecka w usta.
Charakterystyczne dla kandydozy i innych zakażeń grzybiczych są białawe naloty na podniebieniu i wewnętrznych stronach policzków. Naloty mogą objąć także język, dziąsła i kąciki ust. Z zapaleniem jamy ustnej może dodatkowo współistnieć kandydoza gardła i/lub przełyku. Jak wskazują niektórzy naukowcy, w przypadku palaczy istnieje ryzyko zezłośliwienia się zmian.
Kandydoza przełyku
Kandydoza w obrębie przełyku objawia się problemami i bólem w trakcie przełykania, pieczeniem w nadbrzuszu i za mostkiem. Często może dojść do nadmiernego chudnięcia. W przypadku podejrzenia zakażenia warto wykonać endoskopię, aby ocenić nasilenie zmian grzybiczych oraz zbadać wycinki. Zakażenie może obejmować same błony śluzowe przełyku, jednak warto wziąć pod uwagę również zakażenie uogólnione.
Oprócz typowych czynników ryzyka kandydozy w przypadku zajęcia przełyku bierze się również pod uwagę stosowanie inhibitorów pompy protonowej stosowanych w chorobie wrzodowej.
Jak wykryć Candida albicans?
Grzyby z rodzaju Candida można wykryć kilkoma metodami - najczęściej wykonuje się badania serologiczne krwi oraz określa się obecność grzybów (np. mikroskopowo) w różnych materiałach. Rodzaj materiału wybiera się w zależności od podejrzewanej lokalizacji kandydozy.
Badania serologiczne krwi
- Obecność antygenu krążącego we krwi ❱
- Stężenie przeciwciał przeciwko Candida albicans w ramach badania ImuPro Complete ❱
- Stężenie przeciwciał przeciwko Candida albicans w ramach badania IMMUNOdiagDIETA ❱
Wykrywanie obecności Candida w następujących materiałach biologicznych:
- próbka kału - badanie mikroflory jelit ❱
- plwocina (nie może być ślina),
- popłuczyny oskrzelowe, oskrzelikowo-pęcherzykowe, aspirat z tchawicy,
- wymazy np. z cewki moczowej lub szyjki macicy,
- krew i inne płyny ustrojowe (wykonuje się posiew),
- mocz,
- wycinki tkanek (bioptaty),
- zeskrobiny skórne i/lub z paznokci, całe włosy wraz z cebulką.
Dieta przy grzybicy
Widać ewidentną zależność pomiędzy dietą a obecnością drożdżaków z rodzaju Candida w przewodzie pokarmowym. Przede wszystkim znany jest fakt, że węglowodany stanowią doskonałą pożywkę dla wszelkich grzybów. Dlatego najczęściej zaleca się niemal wykluczenie cukrów prostych z diety oraz ograniczenie produktów wysokoskrobiowych.
Badania wskazują również, że różne rodzaje tłuszczów mogą mieć różny wpływ na kandydozę, a także na stosowane w terapii farmaceutyki. Okazuje się, że hamujące działanie na rozrost Candida albicans ma olej kokosowy.
Właściwym działaniem jest przede wszystkim wdrożenie probiotykoterapii, która umożliwi przywrócenie właściwego stanu flory jelitowej. Może wdrożyć do diety suplementację.
Należy jednak pamiętać, że dieta i probiotyki mogą stanowić wyłącznie wsparcie terapii w kandydozie. Patologiczna obecność Candida albicans wymaga długotrwałego leczenia pod kontrolą lekarską ze względu na możliwe zagrożenie dla zdrowia i życia.
Bibliografia:
- Jeziorek M., Frej-Mądrzak M., Choroszy-Król I.:The influence of diet on gastrointestinal Candida spp. colonization and the susceptibility of Candida spp. to antifungal drugs. Rocz Panstw Zakl Hig. 2019;70(2):195-200.
- Gunsalus K.T. et al.: Manipulation of Host Diet To Reduce Gastrointestinal Colonization by the Opportunistic Pathogen Candida albicans. mSphere. 2015; 1(1): e00020-15.
- Podsiadło B., Przondo-Mordarska B.: Diagnostyka zarażeń grzybiczych. Medycyna Praktyczna. [dostęp online]
- Cielniak I., Parczewski M., Rymer W.: Kandydoza (drożdżyca, kandydiaza) układowa. Medycyna Praktyczna. [dostęp online]
- Przyjałkowski W.: Zapalenie opon mózgowo-rdzeniowych (ZOMR). Medycyna Praktyczna. [dostęp online]
- Kuś J., Jankowski M.: Zapalenie płuc wywołane przez Candida. Medycyna Praktyczna. [dostęp online]
- Korkosz M.: Infekcyjne (septyczne) zapalenie stawów. Medycyna Praktyczna. [dostęp online]
- Duława J., Drabczyk R.: Kandyduria. Medycyna Praktyczna. [dostęp online]
- Stępińska J.: Infekcyjne zapalenie wsierdzia. Medycyna Praktyczna. [dostęp online]
- Clinical Effectiveness Group (Association for Genitourinary Medicine and the Medical Society for the Study of Venereal Diseases): AGUM/MSSVD national guideline on the management of vulvovaginal candidiasis.
- Januszewicz W.: Gastroenterologia. Grzybica (kandydoza) przełyku. Medycyna Praktyczna. [dostęp online]
- Lorkowska-Zawicka B.: Grzybicze zapalenie jamy ustnej. Medycyna Praktyczna. [dostęp online]
To badanie będzie pomocne:

W ramach pakietu badamy:
nietolerancji pokarmowej IgG-zależnej
Wyniki do 20 dni roboczych od otrzymania próbki przez laboratorium
2299.00 zł
2527.50 zł
Dostępne testy

W ramach pakietu badamy:
obecność krążącego antygenu Candida w surowicy krwi
Wyniki do 13 dni roboczych
260.28 zł


